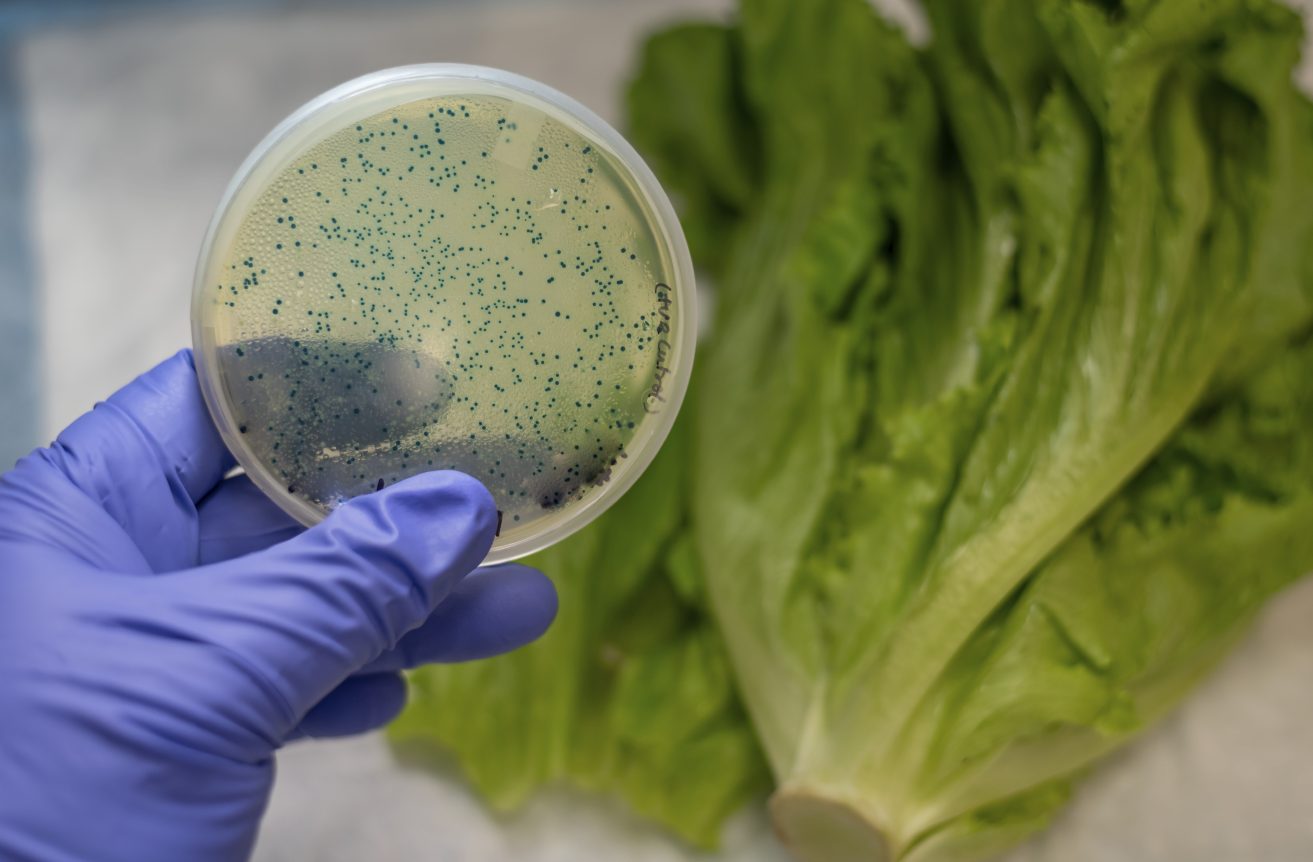
Enfermedades por no lavar los alimentos

¿Cuál es la importancia de tener un purificador de agua en Guatemala?
Guatemala es uno de los países con más recursos hídricos del mundo. Comparado con otros países, está en una posición…
¿Cómo hidratar la piel cuando nada parece funcionar?
Durante los meses de invierno es posible que sientas más sequedad por el frío, sin embargo una buena crema…
4 Enfermedades por no lavar los alimentos con agua limpia
Comer alimentos naturales y preparados en casa es uno de los secretos para mantener la salud y evitar enfermedades, pero…
¿Cuáles son las principales sustancias y contaminantes del agua?
La contaminación del agua es uno de los problemas más graves a nivel mundial, por las repercusiones que esto tiene…
Enfermedades causadas por aguas negras y cómo evitarlas
Actualmente, un alto porcentaje de la población del mundo sufre enfermedades causadas por aguas negras y por la contaminación de…
¿Qué es un aljibe y para qué sirve?
La primera vez que escuché esta palabra me pareció de lo más rara y divertida, no tenía idea de a…